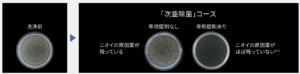

10kgで選ぶなら「家事のラクさ」か「シンプルさ」か
10kgの縦型洗濯機は、家族の普段着からタオル類まで“日常の主力”になるサイズ。
だからこそ、買ってから毎日感じる差は 洗浄力よりも“使い勝手” に出ます。
-
パナソニック NA-FA10K5:計量の手間を減らす自動投入など、“家事ラク寄り”の設計
-
日立 BW-V100M:わかりやすい操作で、洗い上がりにこだわるビートウォッシュ系の“実直派”
同じ10kgでも、向いている人ははっきり分かれます。
どちらが自分に向いているかの参考にしてみて下さい。
▼NA-FA10K5はこちら
▼BW-V100Mはこちら
NA-FA10K5の特長:毎日の「面倒」をごっそり減らす、家事ラク10kg
NA-FA10K5の強みは、“洗濯の前後に発生する小さな手間”を減らして、生活の余白を作るところです。
-
液体洗剤・柔軟剤の自動投入:毎回の計量と投入が不要に。忙しい朝や帰宅後ほど効きます。

-
「スゴ落ち泡洗浄」×「パワフル立体水流」:泡の力と水流で汚れにアプローチ。標準コースでも“ちゃんと洗えた感”を狙う設計。

-
スマホ連携(スマホで洗濯):外出中に終了通知を受けたり、生活リズムに合わせた使い方がしやすい。

-
「次亜除菌」コース:衣類と槽を同時に除菌できるコースが用意されています。
-
設置条件の明確さ:対応防水パン(内寸奥行)などが仕様に明記され、購入前チェックがしやすい。
「洗濯って、結局“回す”より“準備と片付け”が面倒…」という人ほど、NA-FA10K5は満足度が上がりやすいタイプです。
BW-V100Mの特長:迷わせない操作と、日立らしい“洗い方”の安心感
BW-V100Mは、機能を盛りすぎず、でも洗い上がりの理屈はしっかり。いわば“道具として信用できる洗濯機”です。
-
「衣類長もち」ナイアガラ ビート洗浄:洗剤液の浸透を促しつつ、大流量シャワーなどで洗う考え方。10kgを約30分で洗濯する目安も示されています。

-
洗濯槽自動おそうじ(洗濯のたびに洗い流す):見えない部分の汚れに配慮し、清潔を保つ思想。

-
自動投入は“あえて無し”:BW-V100Mには洗剤・柔軟剤の自動投入機能がありません(=タンク手入れが不要で、使い方がシンプル)。
-
設置サイズが比較的コンパクト寄り:幅608mm・奥行610mm・高さ1000mm(メーカー公表)。
「家電に任せすぎるより、自分のペースで“わかりやすく使いたい”」人に、BW-V100Mは刺さります。
▼NA-FA10K5はこちら
▼BW-V100Mはこちら
NA-FA10K5とBW-V100Mのスペック比較(主要ポイントだけ)
| 項目 | パナソニック NA-FA10K5 | 日立 BW-V100M |
|---|---|---|
| 洗濯・脱水容量 | 10kg | 10kg |
| 標準使用水量(目安) | 103L | 103L |
| 消費電力量(洗濯・標準) | 50Wh | 51Wh |
| 目安時間(洗濯・標準) | 34分 | 30分 |
| 運転音(洗濯/脱水) | 32/39dB | 32/39dB |
| 外形寸法(幅×高×奥) | 599×1071×635mm(給排水ホース含む) | 幅608×高1000×奥610mm |
| 本体質量 | 約43kg | 約38kg |
| 洗剤/柔軟剤 自動投入 | あり | なし |
| 防水パン内寸奥行の目安 | 540mm以上 | 530mm以上 |
ポイント:基本性能(10kg・水量・音)は近い一方で、差が出るのは 自動投入の有無/サイズ感/標準時間。
NA-FA10K5に向いている人:洗濯を“考えなくていい家事”にしたい
次のどれかに当てはまるなら、NA-FA10K5がかなり有利です。
-
洗剤の計量が地味にストレス(入れすぎ・こぼす・詰め替え忘れ)
-
朝や帰宅後のバタバタで、洗濯の段取りを減らしたい
-
衣類や槽の清潔面も気になる(コースでケアしたい)
-
スマホ通知などで、生活リズムに合わせて回したい
要するに:「洗濯の手間を“自分の時間”に変えたい人」。
毎日使う家電ほど、“手間が消える価値”は後から効いてきます。
BW-V100Mに向いている人:シンプルに、でも洗い上がりは妥協したくない
BW-V100Mがハマるのは、こんなタイプです。
-
自動投入タンクの手入れや詰まりが気になる/“余計な機能はいらない”
-
標準コースは短め(約30分)で回したい
-
日立の「ナイアガラ ビート洗浄」の洗い方に惹かれる(洗剤液を浸透→シャワー等で洗う思想)
-
高さ1000mmなど、置き場所の条件にシビア(まず入るかが最優先)
要するに:「使い方は簡単なまま、ちゃんと洗える安心感がほしい人」。
“道具として長く使う”選び方に向いています。
▼NA-FA10K5はこちら
▼BW-V100Mはこちら
あなたに合うのはどっち?
最後に、迷いを終わらせるための“選び方”を置いておきます。
-
家事ラク最優先なら → NA-FA10K5(自動投入で手間が減る)
-
シンプル運用&短め運転を重視するなら → BW-V100M(自動投入なしで迷わない)
そして、購入前にこれだけは確認してください。
「置けるか(防水パン内寸・本体寸法)」。ここを外すと、どんな名機でも意味がなくなります。
洗濯機の購入を検討されている方は、参考になれば幸いです。
▼NA-FA10K5はこちら
▼BW-V100Mはこちら

